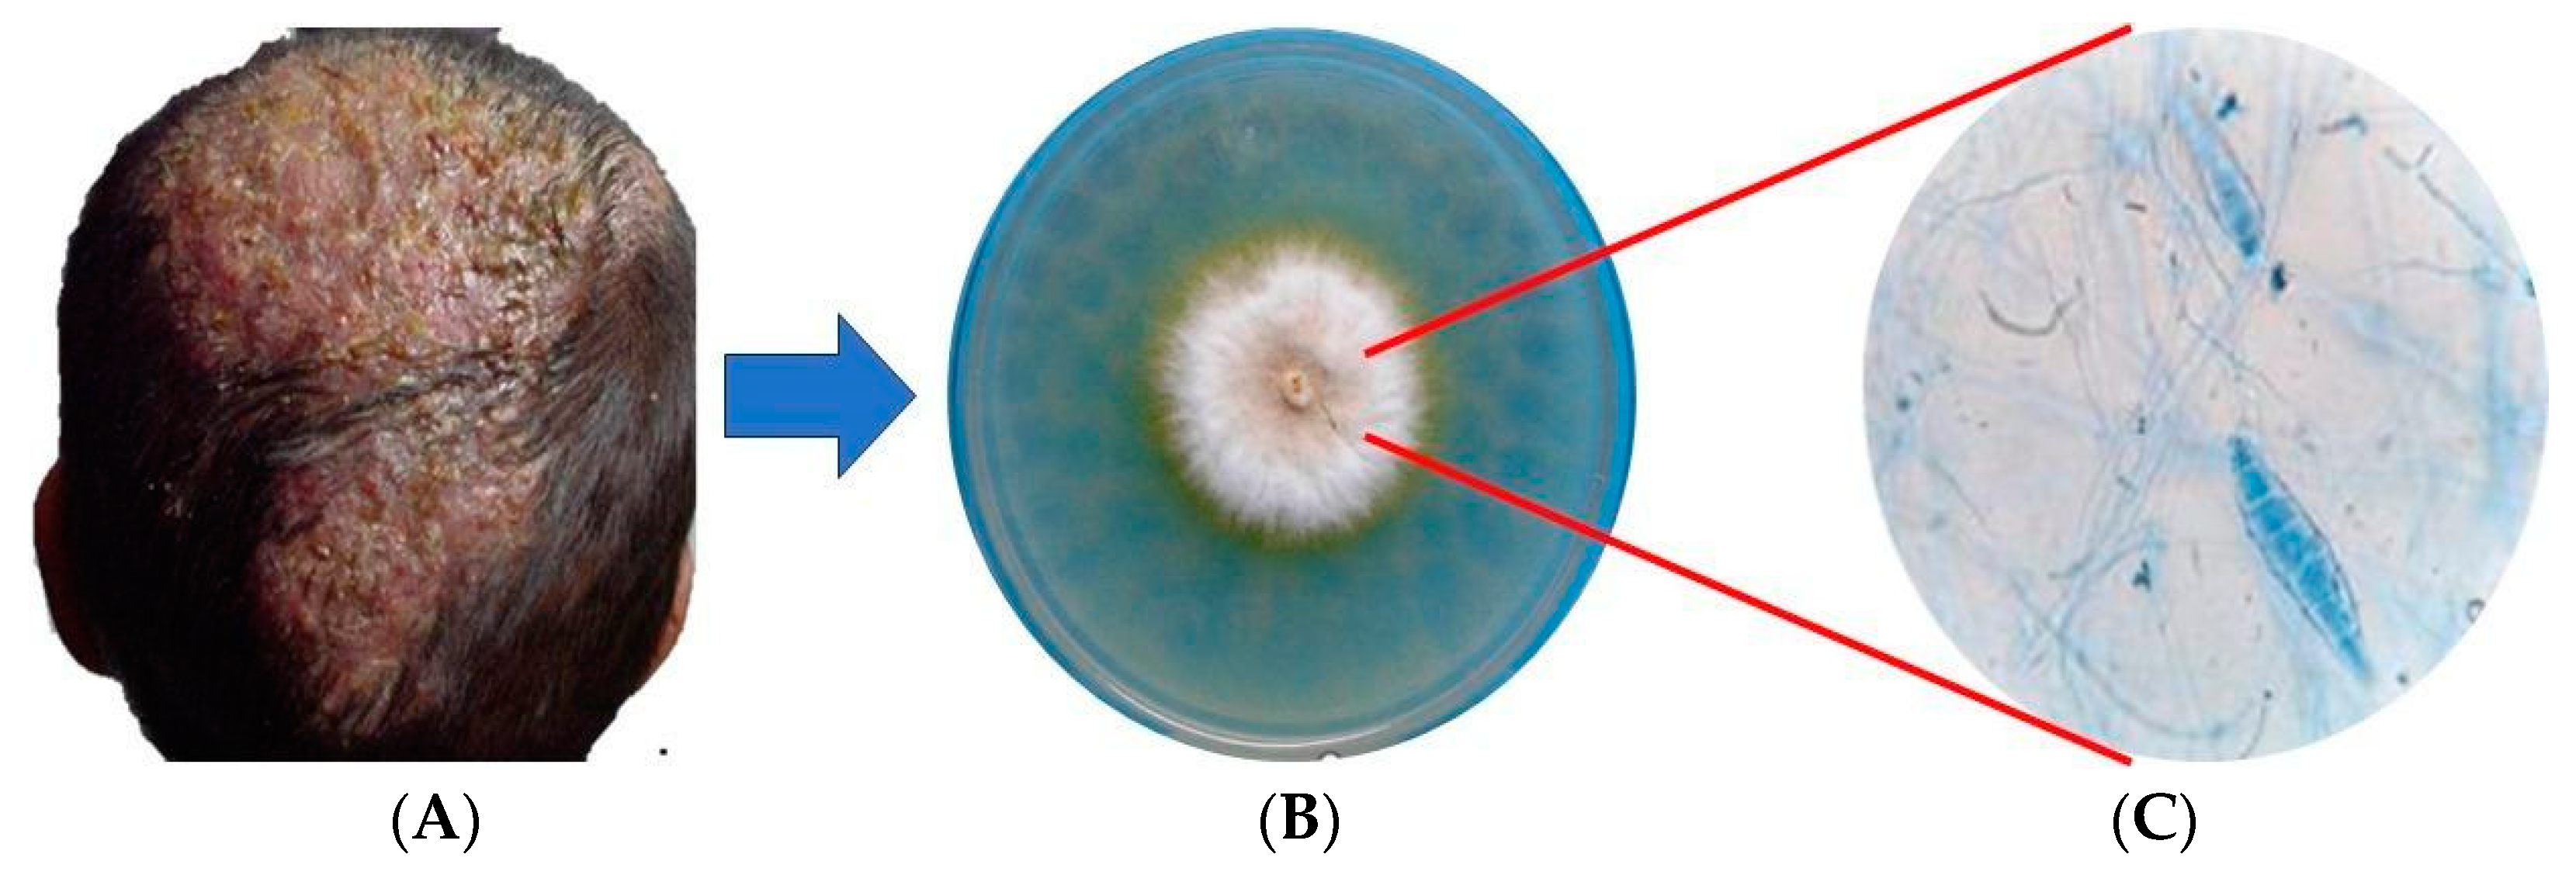
Ijms 25 02533 g001 Ijms 25 02533 g001

Remarkable Phenotypic Virulence Factors of Microsporum canis and Their Associated Genes: A Systematic Review
Abstract
1. Introduction
2. Methods
3. Results
3.1. Extracellular Virulence Factors
3.1.1. Keratinases
3.1.2. Metalloproteases
3.1.3. Subtilisins (Serine Endopeptidases)
3.1.4. Aminopeptidases
3.1.5. Dipeptidylpeptidases
3.1.6. Aspartyl Proteases
3.1.7. Hemolysins
3.1.8. Catalases
3.1.9. Ureases
3.1.10. Serine Hydrolases
3.1.11. Biofilms and Dermatophytomas
3.1.12. Thermotolerance
3.2. Intracellular Virulence Factors
4. Discussion
5. Conclusions
6. Limitations and Perspectives
Author Contributions
Funding
Institutional Review Board Statement
Informed Consent Statement
Data Availability Statement
Conflicts of Interest
References
- Gnat, S.; Łagowski, D.; Nowakiewicz, A.; Zięba, P. Phenotypic characterization of enzymatic activity of clinical dermatophyte isolates from animals with and without skin lesions and humans. J. Appl. Microbiol. 2018, 125, 700–709. [Google Scholar] [CrossRef]
- Ramos, M.L.M.; Coelho, R.A.; Brito-Santos, F.; Guimarães, D.A.; Premazzi, M.G.; Zancopé-Oliveira, R.M.; Pereira, S.A.; Gremião, I.D.F.; Orofino-Costa, R.; Figueiredo-Carvalho, M.H.G.; et al. Comparative analysis of putative Virulence-Associated factors of Microsporum canis isolates from human and animal patients. Mycopathologia 2020, 185, 665–673. [Google Scholar] [CrossRef]
- Sanguino, T.C.; Jarros, I.C.; Negri, M. Occurrence of dermatophytoses in patients from the Sistema Único de Saúde. An. Bras. Dermatol. 2019, 94, 293–297. [Google Scholar] [CrossRef] [PubMed]
- Martínez-Herrera, E.; Moreno-Coutiño, G.; Fuentes-Venado, C.E.; Hernández-Castro, R.; Arenas, R.; Pinto-Almazán, R.; Rodríguez-Cerdeira, C. Main Phenotypic Virulence Factors Identified in Trichophyton rubrum. J. Biol. Regul. Homeost. Agents 2023, 37, 2345–2356. [Google Scholar] [CrossRef]
- Moskaluk, A.; VandeWoude, S. Current topics in Dermatophyte Classification and Clinical Diagnosis. Pathogens 2022, 11, 957. [Google Scholar] [CrossRef] [PubMed]
- de Hoog, G.; Dukik, K.; Monod, M.; Packeu, A.; Stubbe, D.; Hendrickx, M.; Kupsch, C.; Stielow, J.B.; Freeke, J.; Göker, M.; et al. Toward a novel multilocus phylogenetic taxonomy for the dermatophytes. Mycopathologia 2016, 182, 5–31. [Google Scholar] [CrossRef] [PubMed]
- Aneke, C.I.; Rhimi, W.; Hubka, V.; Otranto, D.; Cafarchia, C. Virulence and antifungal susceptibility of Microsporum canis strains from animals and humans. Antibiotics 2021, 10, 296. [Google Scholar] [CrossRef]
- Beigh, S.; Soodan, J.; Singh, R.; Khan, A.A.; Dar, M.A. Evaluation of trace elements, oxidant/antioxidant status, vitamin C and Β-carotene in dogs with dermatophytosis. Mycoses 2013, 57, 358–365. [Google Scholar] [CrossRef]
- Ciesielska, A.; Stączek, P. A new molecular marker for species-specific identification of Microsporum canis. Braz. J. Microbiol. 2020, 51, 1505–1508. [Google Scholar] [CrossRef] [PubMed]
- Martínez, E.; Ameen, M.; Tejada, D.; Arenas, R. Microsporum spp. onychomycosis: Disease presentation, risk factors and treatment responses in an urban population. Braz. J. Infect. Dis. 2014, 18, 181–186. [Google Scholar] [CrossRef]
- Erkan, D.; Kolukırık, I.; Acar, A.; Kandemir, H.; İlkit, M. A recurrent case of adult favus successfully treated with terbinafine. Mikrobiyol. Bul. 2015, 49, 619–624. [Google Scholar] [CrossRef][Green Version]
- Kaplan, E.; Gonca, S.; Kandemir, H.; Döğen, A.; Polat, S.H.; İlkit, M.; Tanaka, R.; Yaguchi, T.; Uhrlaβ, S.; Nenoff, P. Genes encoding proteolytic enzymes fungalysin and subtilisin in dermatophytes of human and animal origin: A comparative study. Mycopathologia 2019, 185, 137–144. [Google Scholar] [CrossRef]
- Khanipour Machiani, M.; Jamshidi, S.; Nikaein, D.; Khosravi, A.; Balal, A. The inhibitory effects of zinc oxide nanoparticles on clinical isolates of Microsporum canis in dogs and cats. Vet. Med. Sci. 2023, 9, e1316. [Google Scholar] [CrossRef] [PubMed]
- Metin, B.; Heitman, J. Sexual reproduction in dermatophytes. Mycopathologia 2016, 182, 45–55. [Google Scholar] [CrossRef] [PubMed]
- Metin, B.; Heitman, J. She loves me, she loves me not: On the dualistic Asexual/Sexual nature of dermatophyte fungi. Mycopathologia 2019, 185, 87–101. [Google Scholar] [CrossRef] [PubMed]
- Sharma, R.; de Hoog, S.; Presber, W.; Gräser, Y. A virulent genotype of Microsporum canis is responsible for the majority of human infections. J. Med. Microbiol. 2007, 56, 1377–1385. [Google Scholar] [CrossRef]
- Page, M.J.; McKenzie, J.E.; Bossuyt, P.M.; Boutron, I.; Hoffmann, T.; Mulrow, C.D.; Shamseer, L.; Tetzlaff, J.; Akl, E.A.; Brennan, S.; et al. The PRISMA 2020 Statement: An Updated Guideline for Reporting Systematic Reviews. BMJ 2021, 372, n71. [Google Scholar] [CrossRef]
- Vermout, S.; Baldo, A.; Tabart, J.; Losson, B.; Mignon, B. Secreted dipeptidyl peptidases as potential virulence factors for Microsporum canis. FEMS Immunol. Med. Microbiol. 2008, 54, 299–308. [Google Scholar] [CrossRef]
- Vermout, S.; Tabart, J.; Baldo, A.; Monod, M.; Losson, B.; Mignon, B. RNA silencing in the dermatophyte Microsporum canis. FEMS Microbiol. Lett. 2007, 275, 38–45. [Google Scholar] [CrossRef][Green Version]
- Lee, K.H.; Park, K.K.; Park, S.H.; Lee, J.B. Isolation, purification and characterization of keratinolytic proteinase from Microsporum canis. Yonsei Med. J. 1987, 28, 131–138. [Google Scholar] [CrossRef][Green Version]
- Lee, K.H.; Lee, J.B.; Lee, M.G.; Song, D. Detection of circulating antibodies to purified keratinolytic proteinase in sera from Guinea pigs infected with Microsporum canis by enzyme-linked immunosorbent assay. Arch. Dermatol. Res. 1988, 280, 45–49. [Google Scholar] [CrossRef]
- Lee, K.H.; Park, H.W.; Lee, J.B. Detection of keratinolytic proteinase in skin tissues from Guinea pigs infected with Microsporum canis by an immunoperoxidase technique. J. Dermatol. Sci. 1990, 1, 447–453. [Google Scholar] [CrossRef] [PubMed]
- Viani, F.C.; Viani, P.R.C.; Rivera, I.N.G.; da Silva, É.G.; Paula, C.R.; Gambale, W. Extracellular proteolytic activity and molecular analysis of Microsporum canis strains isolated of symptomatic and asymptomatic cats. Rev. Iberoam. Micol. 2007, 24, 19–23. [Google Scholar] [CrossRef] [PubMed]
- Sharma, A.; Chandra, S.; Sharma, M. Difference in keratinase activity of dermatophytes at different environmental conditions is an attribute of adaptation to parasitism. Mycoses 2011, 55, 410–415. [Google Scholar] [CrossRef]
- Hamaguchi, T.; Morishita, N.; Usui, R.; Takiuchi, I. Characterization of an extracellular keratinase from Microsporum canis. Nihon Ishinkin Gakkai Zasshi 2000, 41, 257–262. [Google Scholar] [CrossRef] [PubMed][Green Version]
- Monod, M.; Méhul, B. Recent Findings in onychomycosis and their application for appropriate treatment. J. Fungi 2019, 5, 20. [Google Scholar] [CrossRef] [PubMed]
- Baldo, A.; Monod, M.; Mathy, A.; Cambier, L.; Bagut, E.T.; Defaweux, V.; Symoens, F.; Antoine, N.; Mignon, B. Mechanisms of skin adherence and invasion by dermatophytes. Mycoses 2011, 55, 218–223. [Google Scholar] [CrossRef] [PubMed]
- Brouta, F.; Descamps, F.; Monod, M.; Vermout, S.; Losson, B.; Mignon, B. Secreted metalloprotease gene family of Microsporum canis. Infect. Immun. 2002, 70, 5676–5683. [Google Scholar] [CrossRef] [PubMed]
- Brouta, F.; Descamps, F.; Vermout, S.; Monod, M.; Losson, B.; Mignon, B. Humoral and cellular immune response to a Microsporum canis recombinant keratinolytic metalloprotease (R-MEP3) in experimentally infected Guinea pigs. Med. Mycol. 2003, 41, 495–501. [Google Scholar] [CrossRef]
- Mathy, A.; Baldo, A.; Schoofs, L.; Cambier, L.; Defaweux, V.; Tabart, J.; Maréchal, F.; Symoens, F.; Mignon, B. Fungalysin and dipeptidyl-peptidase gene transcription in Microsporum canis strains isolated from symptomatic and asymptomatic cats. Vet. Microbiol. 2010, 146, 179–182. [Google Scholar] [CrossRef]
- Baldo, A.; Tabart, J.; Vermout, S.; Mathy, A.; Collard, A.; Losson, B.; Mignon, B. Secreted subtilisins of Microsporum canis are involved in adherence of arthroconidia to feline corneocytes. J. Med. Microbiol. 2008, 57, 1152–1156. [Google Scholar] [CrossRef]
- Baldo, A.; Mathy, A.; Tabart, J.; Camponova, P.; Vermout, S.; Massart, L.; Maréchal, F.; Galleni, M.; Mignon, B. Secreted subtilisin Sub3 from Microsporum canis is required for adherence to but not for invasion of the epidermis. Br. J. Dermatol. 2010, 162, 990–997. [Google Scholar] [CrossRef]
- Bagut, E.T.; Baldo, A.; Mathy, A.; Cambier, L.; Antoine, N.; Cozma, V.; Mignon, B. Subtilisin Sub3 is involved in adherence of Microsporum canis to human and animal epidermis. J. Vet. Microbiol. 2012, 160, 413–419. [Google Scholar] [CrossRef]
- Baldo, A.; Chevigné, A.; Dumez, M.; Mathy, A.; Power, P.; Tabart, J.; Cambier, L.; Galleni, M.; Mignon, B. Inhibition of the keratinolytic subtilisin protease SUB3 from Microsporum canis by its propeptide (ProSuB3) and evaluation of the capacity of ProSuB3 to inhibit fungal adherence to feline epidermis. Vet. Microbiol. 2012, 159, 479–484. [Google Scholar] [CrossRef]
- Ciesielska, A.; Kawa, A.; Kanarek, K.; Soboń, A.; Szewczyk, R. Metabolomic analysis of Trichophyton rubrum and Microsporum canis during keratin degradation. Sci. Rep. 2021, 11, 3959. [Google Scholar] [CrossRef]
- Descamps, F.; Brouta, F.; Monod, M.; Zaugg, C.; Baar, D.; Losson, B.; Mignon, B. Isolation of a Microsporum canis gene family encoding three Subtilisin-Like proteases expressed in vivo. J. Investig. Dermatol. 2002, 119, 830–835. [Google Scholar] [CrossRef] [PubMed]
- Descamps, F.; Brouta, F.; Vermout, S.; Monod, M.; Losson, B.; Mignon, B. Recombinant expression and antigenic properties of a 31.5-KDa keratinolytic subtilisin-like serine protease from Microsporum canis. FEMS Immunol. Med. Microbiol. 2003, 38, 29–34. [Google Scholar] [CrossRef] [PubMed][Green Version]
- Moskaluk, A.; Darlington, L.; VandeWoude, S. Subtilisin 3 production from Microsporum canis is independent of keratin substrate availability. J. Basic Microbiol. 2024, 64, 22–31. [Google Scholar] [CrossRef] [PubMed]
- Sriranganadane, D.; Waridel, P.; Salamin, K.; Feuermann, M.; Mignon, B.; Staib, P.; Neuhaus, J.; Quadroni, M.; Monod, M. Identification of novel secreted proteases during extracellular proteolysis by dermatophytes at acidic pH. Proteomics 2011, 11, 4422–4433. [Google Scholar] [CrossRef]
- Aktaş, E.; Yiğit, N. Hemolytic activity of dermatophytes species isolated from clinical specimens. J. Mycol. Med. 2015, 25, e25–e30. [Google Scholar] [CrossRef]
- Elavarashi, E.; Kindo, A.J.; Rangarajan, S. Enzymatic and non- enzymatic virulence activities of dermatophytes on solid media. J. Clin. Diagn. Res. 2017, 11, DC23–DC25. [Google Scholar] [CrossRef]
- Wang, R.; Liu, W.; Liu, X.; Wan, Z.; de Hoog, G.S.; Li, R.; Song, Y. Comparative analysis of whole genomes and transcriptomes of Microsporum canis from invasive dermatophytosis and Tinea capitis. Emerg. Microbes Infect. 2023, 12, e2219346. [Google Scholar] [CrossRef]
- Zhang, F.R.; Zhang, Y.; Zhang, Z.Y.; Yang, G.; Jing, L.; Bai, Y. Analysis of the differentially expressed genes in Microsporum canis in inducing smooth skin and scalp tissue conditions. Clin. Exp. Dermatol. 2011, 36, 896–902. [Google Scholar] [CrossRef]
- Zhang, F.; Tan, C.; Xu, Y.; Yang, G. FSH1 regulates the phenotype and pathogenicity of the pathogenic dermatophyte Microsporum canis. Int. J. Mol. Med. 2019, 44, 2047–2056. [Google Scholar] [CrossRef]
- Abdel-Aziz, M.M.; Al-Omar, M.S.; Mohammed, H.A.; Emam, T.M. In vitro and ex vivo antibiofilm activity of a lipopeptide biosurfactant produced by the entomopathogenic Beauveria bassiana strain against Microsporum canis. Microorganisms 2020, 8, 232. [Google Scholar] [CrossRef]
- Brilhante, R.S.N.; de Aguiar, L.; Sales, J.C.; Araújo, G.D.S.; Pereira, V.S.; de Aquino Pereira-Neto, W.; de Queiroz Pinheiro, A.; Paixão, G.C.; de Aguiar Cordeiro, R.; Sidrim, J.J.C.; et al. Ex vivo biofilm-forming ability of dermatophytes using dog and cat hair: An ethically viable approach for an infection model. Biofouling 2019, 35, 392–400. [Google Scholar] [CrossRef]
- Fregonezi, N.F.; Oliveira, L.T.; de Lacorte Singulani, J.; Marcos, C.M.; Santos, C.; Taylor, M.L.; Mendes-Giannini, M.J.S.; de Oliveira, H.C.; Fusco-Almeida, A.M. Heat Shock Protein 60, Insights to its Importance in Histoplasma capsulatum: From Biofilm Formation to Host-Interaction. Front. Cell. Infect. Microbiol. 2021, 10, 591950. [Google Scholar] [CrossRef]
- Galinari, C.B.; Conrado, P.C.V.; Sakita, K.M.; Arita, G.S.; Melo, R.C.; Capoci, I.R.G.; Santos, R.S.D.; Bruschi, M.L.; Kioshima, É.S.; Svidzinski, T.I.E.; et al. New approach to the use of propolis against dermatomycosis. Nat. Prod. Res. 2021, 36, 4215–4220. [Google Scholar] [CrossRef]
- Martínez, E.; Alas, R.; Escalante, K.; Miller, K.; Arenas, R. Dermatofitoma subungueal: Estudio epidemiológico de 100 casos. Rev. Chil. Dermatol. 2010, 26, 22–24. [Google Scholar]
- Brilhante, R.S.N.; Correia, E.E.M.; de Melo Guedes, G.M.; Pereira, V.S.; de Oliveira, J.S.; Bandeira, S.P.; de Alencar, L.P.; de Andrade, A.R.C.; de Souza Collares Maia Castelo-Branco, D.; de Aguiar Cordeiro, R.; et al. Quantitative and structural analyses of the in vitro and ex vivo biofilm-forming ability of dermatophytes. J. Med. Microbiol. 2017, 66, 1045–1052. [Google Scholar] [CrossRef]
- Costa-Orlandi, C.B.; de Cássia Orlandi Sardi, J.; Santos, C.; Fusco-Almeida, A.M.; Mendes-Giannini, M.J.S. In vitro Characterization of Trichophyton rubrum and T. mentagrophytes biofilms. Biofouling 2014, 30, 719–727. [Google Scholar] [CrossRef]
- de Souza Collares Maia Castelo-Branco, D.; de Aguiar, L.; Araújo, G.D.S.; Lopes, R.G.P.; de Alencar Sales, J.; Pereira-Neto, W.A.; de Queiroz Pinheiro, A.; Paixão, G.C.; de Aguiar Cordeiro, R.; Sidrim, J.J.C.; et al. In vitro and Ex vivo Biofilms of Dermatophytes: A new panorama for the study of Antifungal drugs. Biofouling 2020, 36, 783–791. [Google Scholar] [CrossRef]
- de Souza Costa, P.; Basso, M.; Negri, M.; Svidzinski, T.I.E. In vitro and ex vivo Biofilm-Forming ability of Rhinocladiella similis and Trichophyton rubrum isolated from a mixed onychomycosis case. J. Fungi 2023, 9, 696. [Google Scholar] [CrossRef]
- Leesombun, A.; Thanapakdeechaikul, K.; Suwannawiang, J.; Mukto, P.; Sungpradit, S.; Bangphoomi, N.; Changbunjong, T.; Thongjuy, O.; Weluwanarak, T.; Boonmasawai, S. Effects of Coleus amboinicus L. Essential Oil and Ethanolic Extracts on Planktonic Cells and Biofilm Formation of Microsporum canis Isolated from Feline Dermatophytosis. Antibiotics 2022, 11, 1734. [Google Scholar] [CrossRef]
- Neves-da-Rocha, J.; Bitencourt, T.A.; Oliveira, V.; Sanches, P.R.; Rossi, A.; Martinez-Rossi, N.M. Alternative splicing in heat shock protein transcripts as a mechanism of cell adaptation in Trichophyton rubrum. Cells 2019, 8, 1206. [Google Scholar] [CrossRef]
- Sharifzadeh, A.; Shokri, H.; Khosravi, A. In vitro evaluation of antifungal susceptibility and keratinase, elastase, lipase and DNASE activities of different dermatophyte species isolated from clinical specimens in Iran. Mycoses 2016, 56, 710–719. [Google Scholar] [CrossRef]
- Viani, F.C.; Santos, J.I.D.; Paula, C.R.; Larson, C.E.; Gambale, W. Production of extracellular enzymes by Microsporum canis and their role in its virulence. Med. Mycol. 2001, 39, 463–468. [Google Scholar] [CrossRef]
- Ehrlich, F.; Lachner, J.; Hermann, M.; Tschachler, E.; Eckhart, L. Convergent evolution of Cysteine-Rich keratins in hard skin appendages of terrestrial vertebrates. Mol. Biol. Evol. 2019, 37, 982–993. [Google Scholar] [CrossRef]
- Zhao, C.; Xiao, Y.; Ling, S.; Pei, Y.; Ren, J. Structure of collagen. Methods Mol. Biol. 2021, 2347, 17–25. [Google Scholar] [CrossRef]
- Xiao, Y.; Ling, S.; Pei, Y. Structure of Elastin. Methods Mol. Biol. 2021, 2347, 27–33. [Google Scholar] [CrossRef]

| Gene | Protein | Function | Reference |
|---|---|---|---|
| FSH1 | Serine hydrolase | Regulation of metabolism and production of macroconidia | [43,44] |
| PQ-LRP | Membrane protein | Cysteine synthesis | [43] |
| NADH1 | Nicotine Adenine Dinucleotide | Respiratory chain | [43] |
| P-GAL4 | Protein GAL4 | Metabolism of N and production of conidia | [43] |
| AreA | Transcription factor GATA | N metabolism and regulation of proteolytic activity | [39] |
| PacC | pH signaling transcription factor | Regulation of proteolytic activity | [39] |
| SSU1 | Sulfite efflux pump | Cytotoxic compound removal | [5,39] |
| SUB1 | Subtilisin SUB1 | Arthroconidia anchorage to the surface of the host | [12,31,36] |
| SUB2 | Subtilisin SUB2 | Anchoring or adhesion of the arthroconidia to the host’s skin | [12,31,36] |
| SUB3 | Subtilisin SUB3 | Arthrochonidia adhesion | [5,18,19,35,36,37] |
| CDO1 | Cysteindioxygenase 1 | Elimination of cytotoxic compounds | [35] |
| MEP1-MEP5 | Metalloproteases 1 to 5 | Collagenolytic, elastinokeralytic activity and keratinolytic | [12,28] |
| DPPIV and DPPV | Dipeptidylpeptidases IV and V | Polypeptide hydrolysis and degradation of collagen and elastin | [18,19,30,39] |
| LAP1 and LAP2 | Leucinaminopeptidases 1 and 2 | Converting long-chain peptides to amino acids and short-chain peptides | [39] |
Disclaimer/Publisher’s Note: The statements, opinions and data contained in all publications are solely those of the individual author(s) and contributor(s) and not of MDPI and/or the editor(s). MDPI and/or the editor(s) disclaim responsibility for any injury to people or property resulting from any ideas, methods, instructions or products referred to in the content. |
© 2024 by the authors. Licensee MDPI, Basel, Switzerland. This article is an open access article distributed under the terms and conditions of the Creative Commons Attribution (CC BY) license (https://creativecommons.org/licenses/by/4.0/).
Share and Cite
Vite-Garín, T.; Estrada-Cruz, N.A.; Hernández-Castro, R.; Fuentes-Venado, C.E.; Zarate-Segura, P.B.; Frías-De-León, M.G.; Martínez-Castillo, M.; Martínez-Herrera, E.; Pinto-Almazán, R. Remarkable Phenotypic Virulence Factors of Microsporum canis and Their Associated Genes: A Systematic Review. Int. J. Mol. Sci. 2024, 25, 2533. https://doi.org/10.3390/ijms25052533
Vite-Garín T, Estrada-Cruz NA, Hernández-Castro R, Fuentes-Venado CE, Zarate-Segura PB, Frías-De-León MG, Martínez-Castillo M, Martínez-Herrera E, Pinto-Almazán R. Remarkable Phenotypic Virulence Factors of Microsporum canis and Their Associated Genes: A Systematic Review. International Journal of Molecular Sciences. 2024; 25(5):2533. https://doi.org/10.3390/ijms25052533
Chicago/Turabian StyleVite-Garín, Tania, Norma Angélica Estrada-Cruz, Rigoberto Hernández-Castro, Claudia Erika Fuentes-Venado, Paola Berenice Zarate-Segura, María Guadalupe Frías-De-León, Macario Martínez-Castillo, Erick Martínez-Herrera, and Rodolfo Pinto-Almazán. 2024. "Remarkable Phenotypic Virulence Factors of Microsporum canis and Their Associated Genes: A Systematic Review" International Journal of Molecular Sciences 25, no. 5: 2533. https://doi.org/10.3390/ijms25052533
APA StyleVite-Garín, T., Estrada-Cruz, N. A., Hernández-Castro, R., Fuentes-Venado, C. E., Zarate-Segura, P. B., Frías-De-León, M. G., Martínez-Castillo, M., Martínez-Herrera, E., & Pinto-Almazán, R. (2024). Remarkable Phenotypic Virulence Factors of Microsporum canis and Their Associated Genes: A Systematic Review. International Journal of Molecular Sciences, 25(5), 2533. https://doi.org/10.3390/ijms25052533

